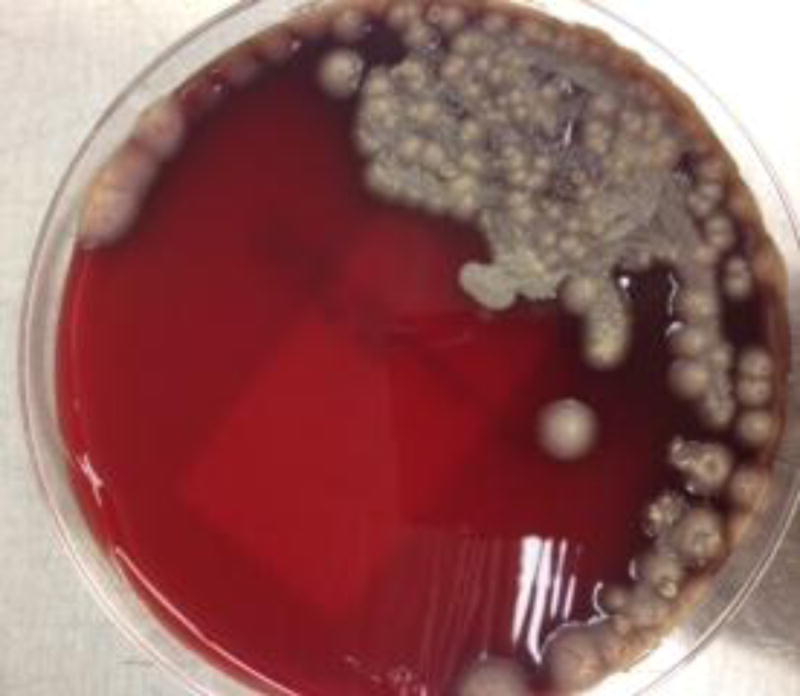
Figure 3

Abstract
Purpureocillium lilacinum is an emerging pathogenic mold among immunocompromised hosts that causes cutaneous infections related to skin-breakdown. We present the first reported case of P. lilacinum tattoo-related skin infection. A kidney transplant recipient recently treated for acute cellular rejection presented with skin papules overlying a tattoo. Diagnosis was confirmed on culture, histology, and 18s ribosomal RNA PCR. The morphological features on culture characteristic of P. lilacinum included violet colonies on malt extract agar, long tapering brush-like phialides, and elliptical conidia attached in chains. P. lilacinum has intrinsic resistance to many antifungal agents including amphotericin B, but voriconazole and posaconazole have good in-vitro activity. The patient was treated with voriconazole with subsequent resolution of the papules after three months of therapy.
Keywords: Purpureocillium, Paecilomyces, solid organ transplant, tattoo
Case Report
A 33-year-old male presented with an eruption of papules overlying a tattoo on his left forearm. The patient had a history of end-stage renal disease from polycystic kidney disease and underwent kidney transplantation a year prior to presentation. Seven months after transplant, he was treated for acute cellular rejection with plasmapheresis, rituximab, and bortezomib. He received the tattoo two months after his rejection episode and the papules appeared three months later. There was no pain, pruritus, or purulence associated with the papules. Over the course of a month, the papules spread from his tattoo to his right ankle and left shin.
Given the rash’s progression, the patient presented to dermatology for further evaluation. He denied any fevers, chills, drenching sweats, cough, shortness of breath, headaches, or vision changes. On examination, temperature was 97.1°F, pulse rate 70 beats per minute, blood pressure 130/72, and respiratory rate 18 breaths per minute. On skin examination, the patient had several 5 mm dome-shaped pink papules clustered over his tattoo (Figure 1). Similar lesions were found on his right ankle and left shin. Laboratory results included a white blood cell count of 3,400 cells/μL with a differential count of 73% polymorphs, 15% lymphocytes, and 9% monocytes. His creatinine was at his baseline level of 1.49 mg/dL. A magnetic resonance imaging of the brain and a computed tomography of the chest, abdomen, and pelvis were normal.
Figure 1.

Skin papules overlying tattoo.
Skin biopsies of the left forearm, right ankle, and left shin were performed. The hematoxylin and eosin stain showed a granulomatous infiltrate with neutrophils. Fungal hyphae were identified on the Grocott’s methenamine silver stain (Figure 2). Wooly colonies with a faint violet color grew on brain heart infusion agar supplemented with blood (Figure 3). A lactophenol cotton blue stain demonstrated septate hyphae with delicate brush-like phialides attached to chains of conidia (Figure 4). Based on the violet colonies and the conidiophore morphology, the patient was diagnosed with a Purpureocillium lilacinum tattoo-related cutaneous infection. The diagnosis was confirmed with 18S ribosomal RNA testing of the tissue culture performed in house. He was treated with voriconazole and his skin papules resolved after three months of therapy (Figure 5).
Figure 2.

(a) Hematoxylin and eosin stain of skin biopsy. (b) Grocott’s methenamine silver stain of skin biopsy.
Figure 3.
Crustose colonies with faint violet color on brain heart infusion agar supplemented with blood.
Figure 4.

Lactophenol cotton blue stain of culture.
Figure 5.

Resolution of papules after three months of voriconazole.
Discussion
Purpureocillium lilacinum, formally known as Paecilomyces lilacinus, is an emerging pathogenic mold found worldwide in soil and decaying vegetation [1–3]. The most common portals of entry include skin breakdown, inhalation, and medical instrumentation [2, 3]. Multiple hospital-acquired P. lilacinum infections have been traced to contaminated medical supplies, including lotions and catheters [4–7]. In our patient, it is assumed the tattoo needle or ink was contaminated, leading to the direct inoculation of P. lilacinum into the dermis. This is the first report of a P. lilacinum tattoo-related skin infection reported in the literature.
P. lilacinum can cause severe disease in both immunocompetent and immunocompromised hosts. Among immunocompetent hosts, the most common clinical presentations are ocular infections (keratitis and endophalmitis) related to ophthalmic surgery and non-surgical trauma [2, 3]. In immunocompromised hosts, cutaneous and subcutaneous infections are the most common clinical manifestations [2, 3]. P. lilacinum cutaneous infections can present as macules, vesicles, pustules, nodules, and necrotic lesions [2, 3]. Other types of P. lilacinum infections include sinusitis, otitis media, pneumonia, endocarditis, catheter-related fungemia, osteomyelitis, and vaginitis [2, 3]. Our patient was at risk of acquiring a P. lilacinum infection secondary to his immunocompromised state related to his kidney transplant and recent treatment for acute cellular rejection.
Diagnosis depends on the identification of P. lilacinum on tissue culture and histology [2, 3]. P. lilacinum is an anamorphic fungus with septate, non-pigmented hyphae when visualized in tissue [2]. Other hyalohyphomycosis agents include Fusarium, Pseudoallescheria, and Scedosporium [2]. A distinguishing feature of P. lilacinum is its ability to produce violet colonies on malt extract agar (the origin of its name) [2, 3]. On microscopic evaluation, the conidiophore has delicate phialides with long tapering necks arranged like a paintbrush and elliptical conidia attached in chains at the ends [2, 3]. Since P. lilacinum can sporulate in tissue, a feature called “adventitious sporulation,” a diagnosis can be made if the characteristic phialides and conidia are identified on histology [3]. In our patient, the fungal infection likely spread from the tattoo to the lower extremities via adventitious sporulation. P. lilacinum can also be identified using molecular techniques including real time PCR and species-specific primers [8].
For the treatment of P. lilacinum infections, an important feature to consider is its intrinsic resistance to many antifungal agents. Amphotericin B, echinocandins, and itraconazole have MICs greater than 16 mg/L against many P. lilacinum isolates [9]. In contrast, voriconazole and posaconazole have good in-vitro activity with MICs ranging from 0.12–8 mg/L and 0.03–1 mg/L, respectively [9]. All case reports on the successful treatment of P. lilacinum cutaneous infection have used voriconazole, but it is likely posaconazole would also be effective given its low MICs in-vitro [10].
Footnotes
Author contributions:
S.A. Trinh: Concept/design, Drafting article, Critical revision of article, Approval of article.
M.P. Angarone: Concept/design, Critical revision of article, Approval of article.
References
- 1.Luangsa-Ard J, Houbraken J, van Doorn T, et al. Purpureocillium, a new genus for the medically important Paecilomyces lilacinus. FEMS Microbiol Lett. 2011;321(2):141–9. doi: 10.1111/j.1574-6968.2011.02322.x. [DOI] [PubMed] [Google Scholar]
- 2.Antas PR, Brito MM, Peixoto E, Ponte CG, Borba CM. Neglected and emerging fungal infections: review of hyalohyphomycosis by Paecilomyces lilacinus focusing in disease burden, in vitro antifungal susceptibility and management. Microbes Infect. 2012;14(1):1–8. doi: 10.1016/j.micinf.2011.08.004. [DOI] [PubMed] [Google Scholar]
- 3.Pastor FJ, Guarro J. Clinical manifestations, treatment and outcome of Paecilomyces lilacinus infections. Clin Microbiol Infect. 2006;12(10):948–60. doi: 10.1111/j.1469-0691.2006.01481.x. [DOI] [PubMed] [Google Scholar]
- 4.Orth B, Frei R, Itin PH, et al. Outbreak of invasive mycoses caused by Paecilomyces lilacinus from a contaminated skin lotion. Ann Intern Med. 1996;125(10):799–806. doi: 10.7326/0003-4819-125-10-199611150-00003. [DOI] [PubMed] [Google Scholar]
- 5.Itin PH, Frei R, Lautenschlager S, et al. Cutaneous manifestations of Paecilomyces lilacinus infection induced by a contaminated skin lotion in patients who are severely immunosuppressed. J Am Acad Dermatol. 1998;39(3):401–9. doi: 10.1016/s0190-9622(98)70315-9. [DOI] [PubMed] [Google Scholar]
- 6.Tan TQ, Ogden AK, Tillman J, Demmler GJ, Rinaldi MG. Paecilomyces lilacinus catheter-related fungemia in an immunocompromised pediatric patient. J Clin Microbiol. 1992;30(9):2479–83. doi: 10.1128/jcm.30.9.2479-2483.1992. [DOI] [PMC free article] [PubMed] [Google Scholar]
- 7.Chan-Tack KM, Thio CL, Miller NS, Karp CL, Ho C, Merz WG. Paecilomyces lilacinus fungemia in an adult bone marrow transplant recipient. Med Mycol. 1999;37(1):57–60. [PubMed] [Google Scholar]
- 8.Atkins SD, Clark IM, Pande S, Hirsch PR, Kerry BR. The use of real-time PCR and species-specific primers for the identification and monitoring of Paecilomyces lilacinus. FEMS Microbiol Ecol. 2005;51(2):257–64. doi: 10.1016/j.femsec.2004.09.002. [DOI] [PubMed] [Google Scholar]
- 9.Castelli MV, Alastruey-Izquierdo A, Cuesta I, et al. Susceptibility testing and molecular classification of Paecilomyces spp. Antimicrob Agents Chemother. 2008;52(8):2926–8. doi: 10.1128/AAC.00538-08. [DOI] [PMC free article] [PubMed] [Google Scholar]
- 10.Rimawi RH, Carter Y, Ware T, Christie J, Siraj D. Use of voriconazole for the treatment of Paecilomyces lilacinus cutaneous infections: case presentation and review of published literature. Mycopathologia. 2013;175(3–4):345–9. doi: 10.1007/s11046-012-9610-3. [DOI] [PubMed] [Google Scholar]
